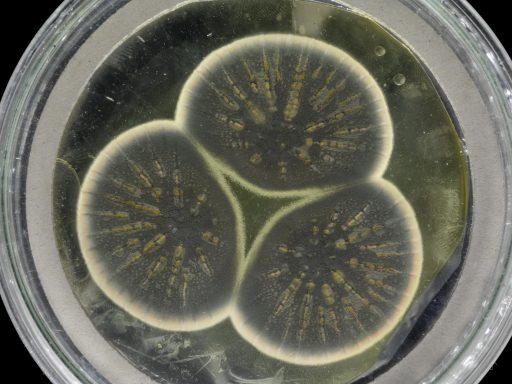
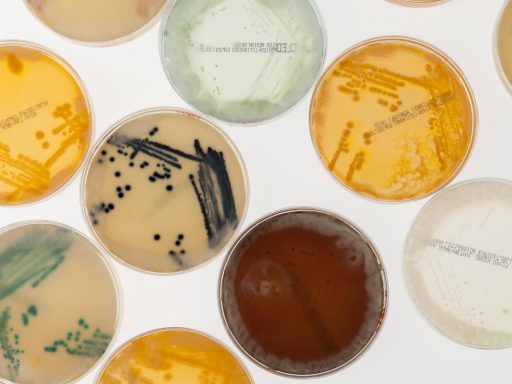

Roger Highfield, Science Director and member of the Longitude Committee, discusses the long-sought winner of the Prize, announced today in the Science Museum.

Roger Highfield, Science Director and member of the Longitude Committee, discusses the long-sought winner of the Prize, announced today in the Science Museum.
Genetic Resource Collection Curator at the Centre for Agriculture and Biosciences International, Matthew Ryan, explores Fleming’s Penicillium and the potential of microorganisms.
We explore alien bacteria, the most likely alien life form we are to find, and how their existence could impact the scientific community.

Digital Editor at the Longitude Prize, Shae Harmon, takes us behind the scenes of her new documentary, ‘Fighting Superbugs in India’.

From dragon’s blood to your own faeces, we explore seven unusual places you might not think to look for the next wave of antibiotics.

Before antibiotics, treating bacterial infections could be nasty and dangerous. Here are 7 eye-watering ways our ancestors tried to battle the bugs.

Contemporary Science Research Volunteer, Claudia Cook looks at how we can harness light from the Sun to create medicine.

Dr Abdul Ghafur explored the future of antibiotic resistance at the Science Museum Illuminating India Lates.

Walk through the ground floor of the Science Museum and you will pass by a little brass box which contains mould donated by Sir Alexander Fleming. Roger Highfield explains more.

Pieter van Boheemen explores how antibiotics research is moving out of the lab and into the hands of the public.

The Science Museum has helped inspire a new game about superbugs. Roger Highfield explains more.

At the 2016 Hay Festival, Director of External Affairs Roger Highfield interviewed the President of the Society, Nobelist Venki Ramakrishnan.